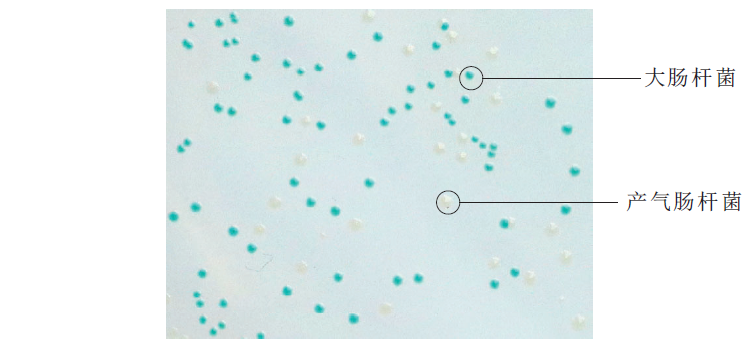

海博微信公众号
海博微信公众号
 海博天猫旗舰店
海博天猫旗舰店


 海博微信公众号
海博微信公众号
 海博天猫旗舰店
海博天猫旗舰店




GB4789.38-2025《食品安全国家标准 食品微生物学检验 大肠埃希氏菌计数》标准将在2025年9月16日正式实施。在大肠埃希氏菌平板计数法中,由原先的将冷却至45℃±0.5℃的结晶紫中性红胆盐琼脂(VRBA)倾注于每个平皿中。小心旋转平皿,将培养基与样品匀液充分混匀。待琼脂凝固后,再加3mL-4ml VRBA-MUG覆盖平板表层。更改为尽快将冷却至48℃±2℃的TBX琼脂倾注与培养皿中,每皿15ml-20ml。小心旋转培养基,将培养基与接种的样品匀液充分混匀,水平静置待其凝固。
现我们比较一下TBX与VRBA-MUG配方
TBX配方

VRBA-MUG配方

两者都具有能和大肠埃希氏菌具有的β-葡萄糖醛酸苷酶进行反应成分。
在TBX培养基中,大肠埃希氏菌具有β-葡萄糖醛酸苷酶活性,能分解5-溴-4-氯-3-吲哚-β-D-葡萄糖醛酸苷,在TBX琼脂上形成蓝绿色菌落,对其进行平板计数和鉴定。在VRBA-MUG培养基中,大肠埃希氏杆菌含有的β-葡萄糖醛酸苷酶作用于4-甲基伞形酮-β-D葡萄糖醛酸苷(4-Methylumbellifery-β-D-Glucuronide简称MUG)的β糖醛酸苷键,使其水解,释放的4-甲基伞形酮在366nm紫外灯下产生蓝白色荧光,然后进行平板计数。
VRBA-MUG培养基观察荧光计数的方法存在一定的局限性,需要用到紫外灯观察,在菌落密集的地方,是一片荧光,不能明显的分辨哪个菌落产生荧光,哪个菌落不产生荧光,故在最后计数时,会产生误差。TBX就很好的解决了这一点,不需要借助紫外灯,即使在菌落密集的地方也能分辨出每个菌落的颜色,使最后计数的结果更加清晰直观。
还有一点是绝大多数大肠埃希氏菌具有β-葡萄糖醛酸苷酶活性,但大肠埃希氏菌O157等菌株没有β-葡萄糖醛酸苷酶活性;另外肠杆菌科内一些志贺氏菌,沙门氏菌等菌株也具有β-葡萄糖醛酸苷酶活性,使我们检验中使用这两种培养基可能存在假阳性和假阴性的风险。
总的来说新标准培养基的更换还是使我们的检验更加简便,从原来的准备两种培养基倾注,变成一种培养基倾注,计数过程也更加轻便,不用使用366nm的紫外灯照射。

注:本文属海博生物原创,未经允许不得转载。
上一篇:大肠杆菌在食品安全领域的影响
| 相关文章: | ||



